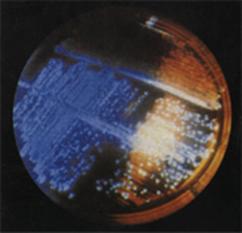

Department of Aquatic Animal Health Management
Training and Consultancy services
The Department also offers short term training programmes in different areas for officers of Government Departments, Technicians from hatcheries and fish processing units and Scientists from universities and research institutions. Some of the areas in which training is offered are
- Shrimp disease diagnosis using PCR and traditional methods
- Bacteriological techniques in aquaculture
- Molecular techniques for rapid detection of pathogens associated with seafoods
- Testing efficiency of probiotics and antimicrobial agents
- Microbiological and biochemical tests of water
- Short term training in Bioinformatics.
The Department provides the following analytical services to the aquaculture and fish processing industries
- PCR testing of shrimp larvae, broodstock, juveniles, pond water, sediment, carrier animal for shrimp viruses such as WSSV, MBV, HPV, YHV.
- Seafood safety assessment: Testing for presence of pathogens - Vibrio cholerae, Salmonella, Staphylococcus aureus, Listeria monocytogenes, Escherichia coli.
- Testing of commercial products intended for use in aquaculture/fish processing systems.
- Analysis of fish/shellfish for biotoxins - PSP, DSP, NSP, ASP, Histamine, Aflatoxins.
- Analysis of drinking water, packaged drinking water.
- Testing shrimp/fish for antibiotic residues by ELISA.
- Industrial water analysis (cooling towers, biofilms) and their effluents from industries such as fish processing, chemicals and fertilizers
Achievements
- Under the DBT funded project, developed a highly efficient immunostimulant for shrimp. The technology has been transferred to industry and the product sold under the brand name "AQUASTIM”.
- Developed for the first time in the country, a highly sensitive and specific diagnostic method based on Polymerase Chain Reaction (PCR) for rapid detection of Whitespot Syndrome Virus ( WSSV ) which is affecting aquaculture industry in Asia. This technology has been transferred to the industry on an commercial basis.
- Played a central role in dissemination of PCR diagnostic techniques in aquaculture sector in India. Having developed PCR diagnostic, trained officers of Marine Products Export Development Authority (MPEDA ) of Ministry of Commerce, Government of India. Helped MPEDA, Government of Andhra Pradesh, Government of Orissa to set up PCR laboratories.
- Help set up PCR laboratories in various shrimp hatcheries.
- Developed a highly sensitive rapid PCR based method for detection of pathogenic strains of Vibrio parahaemolyticus in seafoods. Presently, in the process of training MPEDA and Fish Control Officers in this technology. Filing of patent application in process.
- For the first time developed PCR based detection method for toxic dinoflagellates and their cysts, which cause fish kills and shellfish poisoning.
- First in the country to document Paralytic shellfish toxicity and characterize the toxins by high performance liquid chromatography (HPLC).
Technologies developed
Immunostimulant for shrimp health management (aquastim)
An immunostimulant (Aquasting) containing bacterin, lipopolysaccharides and yeast glucans has been developed. Laboratory studies indicate that administration of the immunostimulant by immersion or through feed stimulates the immune system of shrimp. In hatchery, use of immunostimulant has been shown to improve survival by over 20%
Kit for rapid detection of Vibrio harveyi in hatcheries
 |
 |
|
V. harveyi colonies |
PCR detection of V. harveyi |
A PCR based test for rapid detection of V. harveyi in hatchery water and P. monodon larvae has been developed. This kit would be helpful for assessing the quality of P. monodon larvae and for monitoring eggs, larvae and hatchery water for the presence of this serious pathogen.
PCR kit for detection of white spot syndrome virus, Monodon baculo viruses, Hepatopancreatic parvovirus, infections hypodermal, hematopoietic necrosis virus and laem singh virus have been developed.



Combi kit for simultaneous detection of white spot syndrome virus (WSSV) and monodon baculovirus (MBV)

The COMBI WSSV-MBV is a kit designed to detect very low levels of WSSV and MBV in shrimp by DNA amplification method in a single reaction. The kit employs nested amplification which is 103-104 times more sensitive compared to normal one step Polymerase Chain Reaction (PCR). The method is simple and takes only 6 hrs from sample preparation to the results.
LUMINIL – Bacteriophage therapy
Luminous bacterial disease is caused by Vibrio harveyi one of the greatest problems in shrimp hatcheries and farms. A biocontrol of the Vibrio is developed employing phage theraphy
Luminous bacterial disease is caused by Vibrio harveyi one of the greatest problems in shrimp hatcheries and farms. A biocontrol of the Vibrio is developed employing phage theraphy
Oligonucleotide probe for the detection and enumeration of Vibrio species in aquaculture systems

Colony hybridization
Vibrio species are serious shrimp pathogens causing mortalities in hatcheries and grow out systems. Vibrio counts in hatchery systems and shrimp ponds are considered an indicator of the health of the systems, higher counts indicating poor health. A specific oligonucleotide probe for enumeration of Vibrios by colony hybridization after plating in non-selective agar medium such as Tryptone soya agar has been developed. The DNA probe can be used to detect and enumerate all Vibrio species on any non selective medium. This will facilitate growth metabolically injured Vibrios subjected to sanitizer treatment.
Development of recombinant protein vaccine against Aeromonas hydrophila

Aeromonas hydrophila causes motile aeromonad septicemia which results in great economic losses for the fish-farming industry. A recombinant vaccine developed against this pathogen has provided high protection (RPS ~ 65%) when challenged with A.hydrophila.
Development of recombinant protein vaccine against Edwardsiella tarda

Edwardsiella tarda is responsible for ‘Edwardsiellosis’, a disease characterized by septicemia with extensive skin lesions and swelling in fish. We have developed a recombinant vaccine with high protection (RPS ~70%) when challenged with E.tarda.
Rapid detection of Aeromonas hydrophila by PCR and dot blot


Aeromonas hydrophila has been predominantly involved in warm water fish disease. A PCR based dot blot method for rapid detection of Aeromonas spp. targeting a common gene of all aeromonads has been developed.
Rapid detection of edwardsiella tarda by PCR

A PCR for rapid detection of E. tarda targeting a common gene has been developed.



